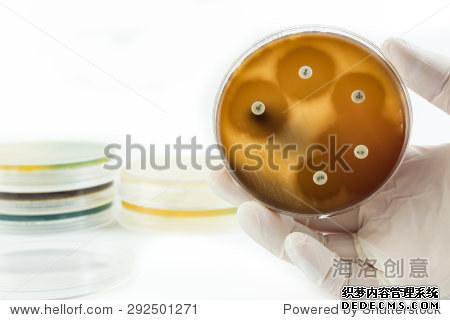

热门文章
随机文章
Jun Koharu携手共进
Jun Koharu携手共进
相关阅读
12人的英语专业词汇:您是谁?
本文由春熙在线英语培训于2017年创建。
2)
27日,编辑发布了世界上最惊人的一部。
没有相关信息中秋节|您知道四个英语版本的中秋节吗?
英语量词有误吗?
看这里!
您真的了解雅思考试的内容吗?
想出国吗?
不要使用英语使用这些错误。
请记住
不要翻译这些短语
谈论循环英语动词-在线英语培训
像徐Ji这样的英语单词可以给你信心_在线英语培训_一对一外国老师
雅思考试7招和灯光_在线英语培训_向1:1外教展示
雅思语法欣赏技术口译员_在线英语培训_一对一外教
雅思口语标准的“力与力” _在线英语培训
柯林斯语法和特殊手册(PDF云资源)
学生钱包又被牺牲了!
从6月15日起免费赠送1个跑步包
北美范式语法“理解和使用英语语法
在谈论雅思考试时,您需要注意以下五点。_在线英语培训_一对一的外国老师
“剑桥雅思考试奖励真正的问题和极端的体育锻炼解码”高清下载PDF
受高清PDF + MP3 Pengfen启发的儿童英语杂志“ HighFive”
成人练习英语有什么好处?
多少钱?
_英语在线培训_外国一对一
您如何选择在线英语培训机构?
谈谈观点
我如何学习在线说英语?很多人不知道的两点
哪个商务英语培训机构更好?
让我告诉你我对春熙外语的看法。
只需背诵30,000个单词和200个单词即可。这是单词的根源
如何在1小时内学习100个单词_英语在线培训_外国人一对一
情态动词和遗嘱有什么区别?
英语成语,富有表现力!
小春行话反应| getafreehand“写意”?
Xiaochun Yiyu的回答| Apiginapoke≠“在猪的口袋里”
看这里!
我会教你成为英语姐妹!
研究生英语|面试技巧
了解实用的电话英语!
小春的行话反应| Makeapig'sear≠“猪耳”

12人的英语专业词汇:您是谁?
本文由春熙在线英语培训于2017年创建。
2)
27日,编辑发布了世界上最惊人的一部。
没有相关信息中秋节|您知道四个英语版本的中秋节吗?
英语量词有误吗?
看这里!
您真的了解雅思考试的内容吗?
想出国吗?
不要使用英语使用这些错误。
请记住
不要翻译这些短语
谈论循环英语动词-在线英语培训
像徐Ji这样的英语单词可以给你信心_在线英语培训_一对一外国老师
雅思考试7招和灯光_在线英语培训_向1:1外教展示
雅思语法欣赏技术口译员_在线英语培训_一对一外教
雅思口语标准的“力与力” _在线英语培训
柯林斯语法和特殊手册(PDF云资源)
学生钱包又被牺牲了!
从6月15日起免费赠送1个跑步包
北美范式语法“理解和使用英语语法
在谈论雅思考试时,您需要注意以下五点。_在线英语培训_一对一的外国老师
“剑桥雅思考试奖励真正的问题和极端的体育锻炼解码”高清下载PDF
受高清PDF + MP3 Pengfen启发的儿童英语杂志“ HighFive”
成人练习英语有什么好处?
多少钱?
_英语在线培训_外国一对一
您如何选择在线英语培训机构?
谈谈观点
我如何学习在线说英语?很多人不知道的两点
哪个商务英语培训机构更好?
让我告诉你我对春熙外语的看法。
只需背诵30,000个单词和200个单词即可。这是单词的根源
如何在1小时内学习100个单词_英语在线培训_外国人一对一
情态动词和遗嘱有什么区别?
英语成语,富有表现力!
小春行话反应| getafreehand“写意”?
Xiaochun Yiyu的回答| Apiginapoke≠“在猪的口袋里”
看这里!
我会教你成为英语姐妹!
研究生英语|面试技巧
了解实用的电话英语!
小春的行话反应| Makeapig'sear≠“猪耳”